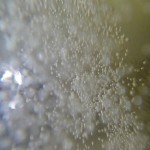
this-is-the-inside-of-your-beer

Bachelor Party…goodnight sweet prince
For those of you not keeping score at home (or reading super SEO’d blog titles…above) FWG took a group trip to The Dogfish Head Brewery in wonderful Milton, Delaware. And this wasn’t just any tour, this was part of a three day bachelor party-beach-extravaganza with former players representing the Big East, MAC, and NFL…and Pennsylvania AAA High School Football. This many meatheads in a confined space has bro-tastic disaster written all over it, add in the fact that three years removed from college/pro football and they’ve all managed to put a little coin in their respective cargo shorts and I’m lucky we (I) made it out alive. Me and my co-pilot Mike left Thursday night after work and managed to get lost only once (fuck you George Washington Bridge Upper Level Barricade) before arriving at 3:07am Friday morning.
Having full expected to see a bunch of passed out party animals who’d arrived 12-16 hours prior, Mike and I steeled ourselves as we tore gravel to our beach front destination. “Let’s get in…find the nearest couch-mattress-plot of soft grass…and crash for the night. We’ll wake up everyone, cook breakfast and show these clowns what UConn does…”
Welp, Gee….imagine our surprise when we were greeted at the end of said driveway by what appeared to be a human Weeble-Wobble or just someone who’d enjoyed precisely 12-16 hours of partying prior to our grand arrival. In a very Belushi-esque moment the party in question managed to utter “Grab a beer…it don’t cost nothin'”
And so we did. Several dozen. Over three days.
Needless to say when the celebrating the death of a fellow man’s bachelor-hood starts on Thursday, by Saturday you’ve eaten all the processed meat, nachos, fried chicken and snickers bars (not in that order) in the Tri-State area.
It also means that come Saturday morning, say, 10:15am you’re fighting any notion of being active for the day, let-alone a contributing member of society. It also just so happens that Saturday was when we schedule our tour for Dogfish Head. I will say that if you had to pick one thing to do on a hung over Saturday in Delaware, when rounds of alcoholic consumption combined with pasta dinners have bloated you to John Candy-esque proportions thus negating any idea of going to the beach, the one thing you can and should do is go to a brewery. We were lucky one of the Country’s best was only 20 minutes away.
Hair Of The Dog
(see what I did there?)

I’d like to say I’m some sort of beer expert, with a palate that would make even the finest sommelier blush with inadequacy. Unfortunately, I’m not. But I do know and love good beer, and this is entirely on accident. Raised on Labatt, drank Keystone through college, my taste for hops and barley was more about price point then quality “Ah-ha! Good sir! I see Schlitz is on special….” I accidentally tried Dogfish Head while trying to buy bait for a fishing trip (saw a fish in the window…got tricked…blah blah blah). I’ve been a devoted Fish-head ever since.
I’ve written (love) letters to the owner, Sam Calagione who’s reply was not only warm-hearted but also where this whole adventure began.
Sam put me in touch with Connie, who set up the tour, and so on and so fourth.
Like their beer, Dogfish Head Brewery’s employees were of the highest quality: knowledgeable, friendly, and understanding of a hordes of hungover former footballers. I loved everything about being there. We were shown the bottling line, the different brew (and special) brew tanks, and our favorite part of the trip: sampling their different brews. Absolutely tremendous.
Our tour guide, Kristen was not intimidated (or didn’t let on) by giving 15 men reeking of fried food and hooker sweat a private tour of the inner workings of the operation. In fact, always a good sport she even jibbed our taller friends (6’7 and 6’8 respectively) “Hey Sasquatch…”

Thanks Kristen, seriously.
Dogfish Head is still a small brewery, even though they’ve expanded considerably since their kitchen-sink-brew-pub beginnings. The demand for their liquid gold far exceeds the supply, which drives their growth (about 30% every year…or so I was told). It’s not hard to see why: their beer ranges from Dark-as-motor-oil to light and hoppy (I suggest the 60 minute IPA) and yet all delicious.
I encourage you to poke through the gallery below. I wish I had more photos to share, but the rest were…lost. “Yes, sweety….Golf, Dinner…and then we all turned in for the night…boring, really.”
Anyway, a big thank you to Sam Calagione, Connie Park, Mark Carter, and Kristen Coughlan for their help. Cheers!

Leave a comment